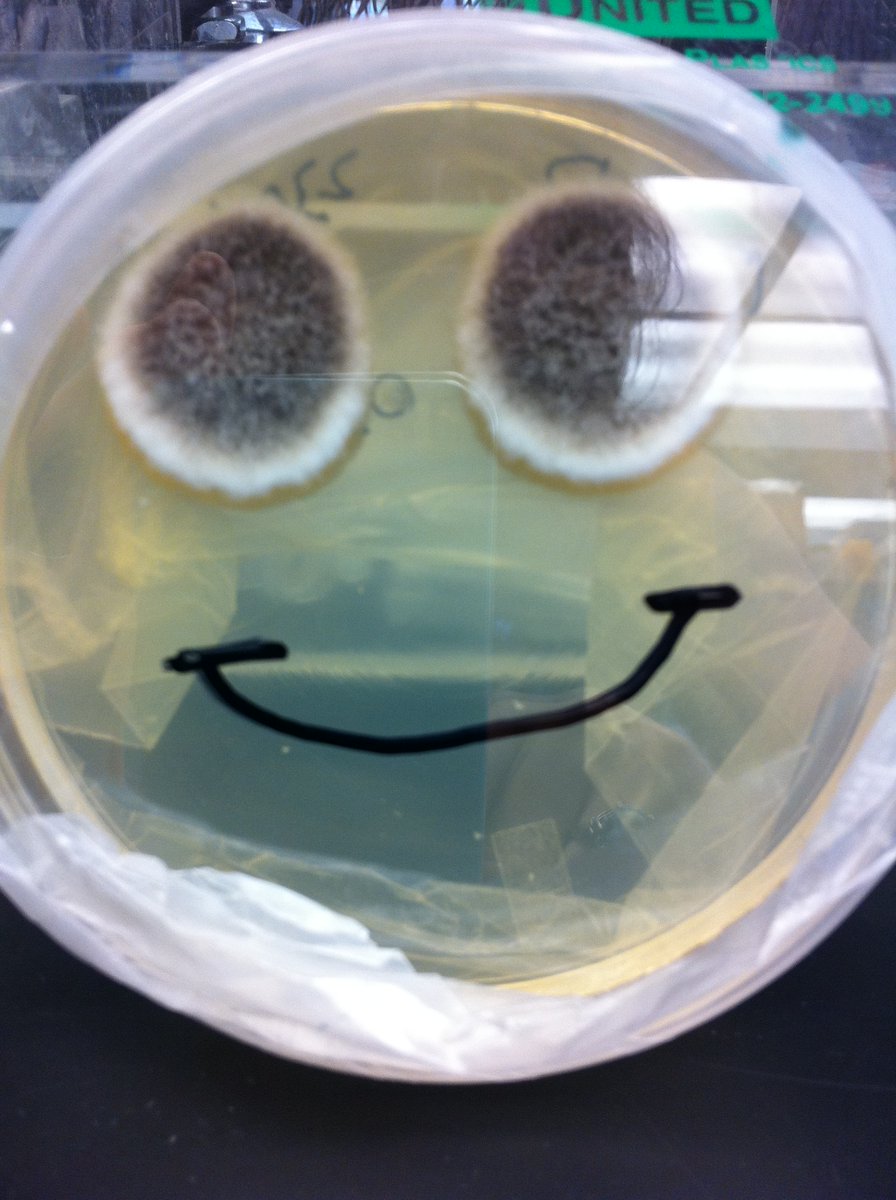

CHP PedSDP
@chppedsdp
The official twitter of the CHP Pediatric Scientist Development Program
ID: 1278330415502307328
https://www.chp.edu/health-care-professionals/education/residencies/pedsdp 01-07-2020 14:11:56
93 Tweet
172 Followers
100 Following



Our rheumatology fellow Katie (Catherine) Poholek was selected to present her interesting patient case at the American College of Rheumatology annual meeting! Way to go! 👏🏻👏🏻👏🏻



Looking for a truly infectious pediatric subspecialty fellowship? Children's Hospital of Pittsburgh ID Division fellowship position available UPMC Children's Hospital of Pittsburgh to start July 2022! #pedsID #pedsresidency #IDtwitter #medtwitter #tweetiatrician FuturePedsRes Bol Gach PIDS IDSA Foundation

Congrats future #tweetiatricians on certifying those rank lists! We can’t wait to welcome our future #peds residents to CHP Pediatrics Residency soon! #Match2022 #physicianscientist



Next talk is our own Sydney Rooney from CHP PedSDP and CHP Pediatrics Residency to talk about her #MachineLearning work on a fib in adults


It’s happening! Our SIXTH CHP PedSDP retreat for 17 members of the track at CHP Pediatrics Residency at UPMC Children's Hospital of Pittsburgh. We will celebrate grads (@mcfreeID et al) and our four fab incoming interns!



Huge congrats 🎉 to our grads Drs Freeman, Poholek, and Rapsinski! They have made our program what it is…and all 3 are staying at Pitt Department of Pediatrics and UPMC Children's Hospital of Pittsburgh ! @mcfreeID Katie (Catherine) Poholek CHP PedSDP






This year, U.S. News & World Report ranks UPMC Children's #6 on its "Best Children's Hospitals" Honor Roll. We're one of only 10 children's hospitals in the country to receive this honor roll recognition. Children's also ranked in 10 of 10 specialties, including 6 in their respective top 10.


Congratulations Allan Joseph (@allanmjoseph.bsky.social) on your first author paper - rising PedsICU_tweets policy researcher ⭐️ PALISI @NICHD_NIH